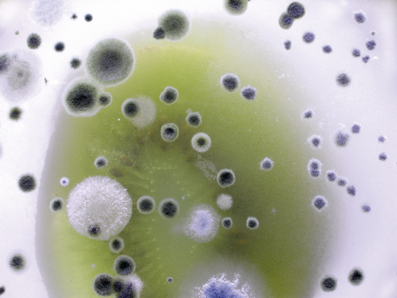
HET Likvisan biocidní přípravek proti plísním a řasám - ukázka 3

Popis
HET Likvisan biocidní přípravek proti plísním a řasám určený k sanaci plísní nebo řasami napadených vápenných, vápenocementových a sádrových omítek, zdiva, sádrokartonových, sádrovláknitých, dřevotřískových, dřevovláknitých, betonových či kamenných stavebních konstrukcí, zdí opatřených tapetami apod. v interiéru i exteriéru. Přípravek lze použít zejména v koupelnách, prádelnách, sklepech, v prostředí s vysokou vlhkostí, v sanačních systémech atd. Neobsahuje anorganicky vázaný chlór, který by způsoboval vznik nežádoucích hygroskopických solí vedoucích k zasolování a následnému zvyšování vlhkosti zdiva. Přípravek nemá bělící účinky. Výrobek je konzervačním přípravkem pro zdivo (PT10).
Výhody
- Účinná sanace plísní a řas různého původu
- Prevence vzniku napadení
- Bez bělících účinků
- Nezasoluje zdivo
- Vhodný do interiéru i exteriéru
- Vydatnost 4 - 10 m²/l
- Neředí se, připraven k okamžitému použití
Doba schnutí
Čas potřebný pro biocidní účinek: nejméně 6 hodin po nanesení roztoku.
Aplikace
Prvním krokem sanačního postupu by mělo být usmrcení plísní ve smyslu jejich mechanického odstranění. Plíseň se na napadených plochách za sucha nesmí odstraňovat, aby nedošlo k vdechování zdraví škodlivých výtrusů plísní a kontaminaci okolí. Napadená místa se namočí přípravkem a plíseň se opatrně odstraní například. špachtlí. Při aplikaci v interiéru v průběhu nanášení a schnutí je nutno zajistit důkladné větrání. Odstranění plísní je nutno provádět do maximální možné hloubky. Na obnažený podklad se opět aplikuje přípravek LIKVISAN, aby aktivní složky mohly proniknout až k plísňovému myceliu hluboko v substrátu. V případě silného napadení lze přípravek aplikovat i vícekrát. Přípravek se nechá působit minimálně 6 - 12 hodin. Při sanaci napadeného zdiva je vhodné použití přípravku kombinovat s přetřením nátěrovou hmotou HETLINE SAN ACTIVE (v interiéru) nebo MIKRAL RENOVO ACTIVE (v exteriéru), které jsou ošetřeny biocidním přípravkem. Při kontaminaci řasami je postup stejný jako při likvidaci plísní. Přestože přípravek nemá bělící účinky a zbytky plísní či řas tak mohou být i po ošetření viditelné, není tímto nijak snížena biocidní účinnost přípravku.
Před sanací biologicky napadeného zdiva je v první řadě nutné určit a odstranit primární příčiny výskytu plísní či řas, které rostou a množí se tam, kde mají zajištěn i minimální zdroj živin, příznivou teplotu, ale především vlhkost. Často jejich výskyt souvisí se špatně dodržovanými vlhkostně teplotními podmínkami vnitřního prostředí člověka (přechod na jiný typ topení, snížení intenzity větrání apod.). Další část primárních příčin souvisí se špatně udržovaným objektem, technickými vadami při stavbě, při rekonstrukcích (nedodržení technických norem na tloušťku obvodové konstrukce, vznik tepelných mostů, nevhodné či špatně provedené izolace základů a střešních krytin, nevhodná výměna oken a mnoho dalších). Při rozsáhlejších sanacích je nutno provést kontrolu účinku (mykologický, algologický a bakteriologický rozbor povrchů). Při likvidaci plísní a řas je nutno asanovat celé prostředí jejich výskytu s celkovým dezinfekčním úklidem - t. j asanace kompletní oblasti výskytu jako je např. obytný blok, čtvrť a pod.
Doporučené pracovní prostředky
Nářadí pro aplikaci: štětkou, příp. malířskými válečky; malé plochy - štětcem, savou tkaninou nebo pomocí rozprašovače.
Dostupné balení: 0,5 l; 1 l; 5 l
Soubory ke stažení
Technické parametry
| Vydatnost | 4 - 10 m²/l |
| Čas potřebný pro biocidní účinek | nejméně 6 hodin po nanesení roztoku |